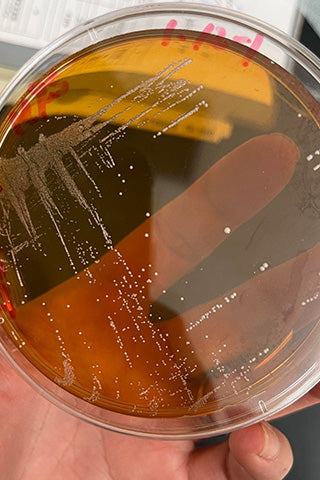
Re:vive Origin アカツキ

- 日本酒通販はSAKE Street
- 【Re:vive、Layer】平六醸造(岩手県)
- Re:vive Origin アカツキ
Re:vive Origin アカツキ
めざめよ、アカツキ
平六醸造の醸造拠点である「日詰平井邸」。100年前まで、平井家が酒造りを営んでいた重要文化財の建物です。その日詰平井邸で、100年の眠りから目覚めた蔵付酵母「アカツキ」を使用したクラフトサケがついにリリースされました。

醸造所開設前の2023年初夏から、岩手県工業技術センターの協力を得てはじまった、蔵付酵母を探す活動。2度のチャレンジを経て、ようやく1株だけ清酒酵母が見つかりました。

その酵母は
・清酒酵母(Saccharomyces cerevisiae)であること
・泡あり酵母であること
・協会酵母ではないこと
・岩手県で頒布されている酵母ではないこと
・その他の頒布されている酵母ではないこと
という条件を全て満たしており、日詰平井邸で酒造りが行われていた頃に、蔵に棲みつき生き残った酵母である可能性が極めて高い、とのこと。
一般的な清酒製造においては1~2種の原料米を使用することが多いことに比べ、目的に合わせて個別に5種の原料米を使用しています。発芽玄米「ヒメノモチ」にはじまり、酒母用掛米は栄養豊富な一般品種を低精白で、麹用米は糖化酵素を引き出し清楚な味わいに仕上げる吟醸精米。もろみの大半を占める掛米は大吟醸クラスの高精白を使用。すべては造り得る最高の酒を求めて、手間もコストも顧みず挑戦する意欲作です。
100年の歴史を経て、現代の醸造家・醸造技術により復活するお酒。
このロマンを味わうチャンスをお見逃しないように!
テイスティングコメント
リンゴや和梨を思わせるような瑞々しい果実香やかすかに瓜系の青い香り、後半にかけ果実系の酸い香りも感じられます。
口に含むときめ細やかで穏やかな発泡感。白桃のような儚い甘さにキャッチーで可憐な酸のアタック。瑞々しくクリアな余韻が広がります。後半にかけ繊細な旨味が広がり、ほろ渋さ等のニュアンスが味わいに立体感を生み出していきます。余韻も美味しい、是非香りのとれるワイングラス等でお楽しみいただきたい1本!
※クール便での発送をおすすめしております。
※お届き次第冷蔵庫にて保管をお願いいたします。
仕様
| 原料 | 米・米麹・発芽玄米 |
|---|---|
| アルコール度数 | 14% |
| 日本酒度 | - |
| 酸度 | - |
| アミノ酸度 | - |
| 使用米・精米歩合 | 「ヒメノモチ」発芽玄米 「あきたこまち」精米歩合80%(酛掛米) 「ぎんおとめ」精米歩合50%(麹用) 「ぎんおとめ」精米歩合40%(掛米) 「ヒメノモチ」精米歩合90%(掛米) |
| 酵母 | アカツキ |
| 酒母 | 発芽玄米使用酒母 |
平六醸造(「Re:vive」「Layer」)について
岩手県紫波町に佇む重要文化財・日詰平井邸で、若き醸造家・平井佑樹さんが立ち上げた「平六醸造」。その歴史と情熱が詰まったクラフトサケ「Re:vive」は、発芽玄米麹を用いた唯一無二の味わい。サブブランドの「Layer」では、さらにブドウやリンゴなど多彩な副原料を自由に加え、豊かな味わいを表現します。伝統と革新が交差するこの場所で、平井さんの手で蘇るお酒は、人々をつなぎ、新たな物語を紡ぎます。豊かな自然と共に育まれたお米から生まれるこのお酒は、心に響く体験をもたらします。
- 日本酒通販はSAKE Street
- 【Re:vive、Layer】平六醸造(岩手県)
- Re:vive Origin アカツキ